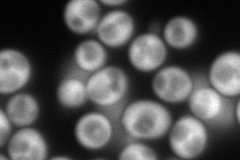
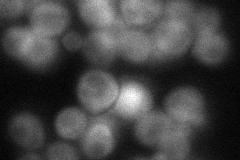
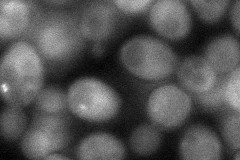
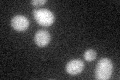

View description
Subunit 6 of the ubiquinol cytochrome-c reductase complex, which is a component of the mitochondrial inner membrane electron transport chain; highly acidic protein; required for maturation of cytochrome c1
Localization:
Intensity:
Fold change:
Significance:
-
C’ GFP library in SD

below threshold14.89 -
N' NOP1pr-GFP in SD
cytosol256.944 -
N' TEF2pr-mCherry in SD

cytosol270.205 -
N' NATIVEpr-GFP in SD
cytosol55.5497 -
N' TEF2pr-VC and Cyto-VN in SD
cytosol53.6868 -
C’ GFP library in SD+DTT
cytosol14.610.98No -
C’ GFP library in SD+H2O2

cytosol15.161.01No -
C’ GFP library in Starvation Media

cytosol14.951No -
C’ GFP library on the background of Pup2-DaMP

below threshold -
C’ GFP library on the background of CCT mutant

below threshold15.56161.04437No
